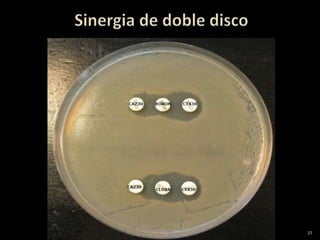
27

El documento describe diferentes tipos de bacterias gramnegativas que causan infecciones urinarias y su resistencia a antibióticos. Explica que Escherichia coli y Klebsiella pneumoniae son los principales agentes causales y que han ido desarrollando resistencia a diferentes antibióticos como las cefalosporinas y carbapenémicos. También describe pruebas fenotípicas para detectar enzimas beta-lactamasas de espectro extendido y carbapenemasas que confieren resistencia a múltiples antibióticos.